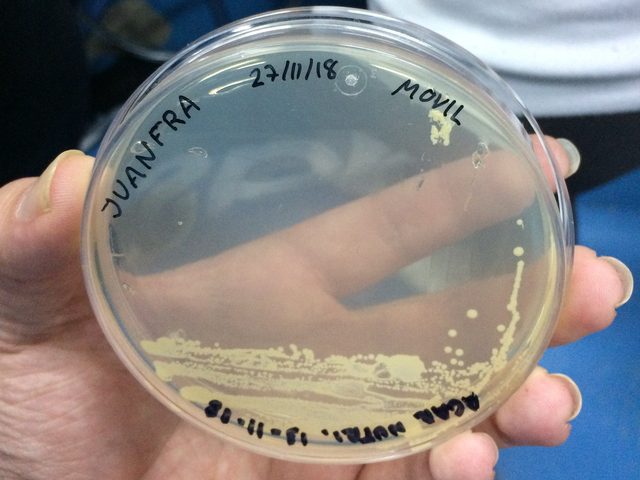
Creación de las placas de Petri.

Evidencia 1. Timeline Químico Bacteriólogo Parasitólogo. EQUIPO 5. CONTEXTO SOCIAL ENERO-JUNIO 2021
-
Fue Antón van Leeuwenhoek, un comerciante holandés que a finales del siglo XVII descubrió́ la vida microscópica. Sin estudios universitarios, Leeuwenhoek fue el primero en ver animales unicelulares, bacterias, glóbulos rojos y espermatozoides. Y todo con sus microscopios caseros, y una curiosidad insaciable, como únicos instrumentos.
-
En su libro El químico escéptico Boyle planteo la hipótesis de que la materia está formada por átomos y agrupaciones de átomos en movimiento, que había mas de 4 elementos y alentó a los químicos a experimentar, Abogó por un acercamiento riguroso a la experimentación científica: creía que todas las teorías deben ser probadas experimentalmente antes de ser consideradas como verdaderas.
-
Marcello Malpighi realizó uno de sus más grandes descubrimientos al encontrar las conexiones de capilares arteriales y venosos pulmonares a los que describe como “tubos” y explica como la oxigenación ocurría en los vasos sanguíneos, confirmando la teoría de Wi-lliam Harvey
-
Fue Antón van Leeuwenhoek, un comerciante holandés que a finales del siglo XVII descubrió́ la vida microscópica. Sin estudios universitarios, Leeuwenhoek fue el primero en ver animales unicelulares, bacterias, glóbulos rojos y espermatozoides. Y todo con sus microscopios caseros, y una curiosidad insaciable, como únicos instrumentos.
-
Lazzaro Spallanzani refutó la teoría de la generación espontánea y señaló que el aire puede transmitir microorganismos que luego se desarrollan en un medio adecuado.
-
El médico inglés Edward Jenner descubrió una forma de proteger a las personas de la viruela y esto llevó al desarrollo de la primera vacuna contra la viruela.
-
Con su publicación “Ommis cellula e cellula” Rudolf Virchow postuló que todas las células provienen de otras células, contribuyó al tercer enunciado de la teoría celular y sustituyó la teoría de Schwann de la procedencia de citoblastema
-
La tabla periódica permitió ordenar los elementos químicos conocidos en un orden creciente, separados por familias, lo que ayudo en el estudio de los mismos, Mendeléyev en su tabla incluso dejo huecos en los lugares donde parecía faltar un elemento aun no descubierto y realizo predicciones muy certeras sobre sus propiedades.
-
Demuestra que la causa de contaminación de cultivos estériles se debe a la presencia de partículas trasportadas por el aire. Desarrolla el método sistema de esterilización por calentamiento discontinuo conocido actualmente como Tindalización.
-
Julius Richard Petri un microbiólogo y médico alemán ideó un medio sólido capaz de aislar las células y conseguir un campo de cultivo puro: las placas de Petri
-
J. Jacobson propuso el uso de ácido crómico para tratar las piezas que iban a ser observadas, con el ob-jeto de endurecerlas y poder observarlas por microscopía, lo que favoreció a los estudios en histología. Esta técnica fue considerada la primera fijación histológica.
-
Una de las tinciones más utilizadas para la clasificación de bacterias es la tinción de Gram, que fue descubierta por el científico Christian Gram
-
En 1905 se funda el Instituto Bacteriológico Nacional de México, con el objetivo de conocer los causantes de enfermedades del país y así crear sueros y vacunas.
-
Alexander Fleming, descubre accidentalmente la penicilina, siendo este el primer antibiótico de la historia.
-
La primera asa metálica calibrada de las que se tiene conocimiento fue descrita en 1928. Se emplea para transportar, arrastrar, trasvasar inóculos (pequeño volumen que contiene microorganismos en suspensión) desde la solución de trabajo también llamada “solución madre” al medio de cultivo (sólido o líquido) o de un medio a otro (resiembra).
-
La Facultad de Ciencias Biológicas nace como Escuela de Ciencias Biológicas el 19 de septiembre de 1952, bajo el amparo del Instituto de Investigaciones Científicas, dependiente de la. Facultad de Filosofía, Ciencias y Letras de la Universidad de Nuevo León. Su fundador fue el Dr. Eduardo Aguirre Pequeño.
-
Marcello Malpighi propuso el uso del microscopio que fue invento del holandés Zacarías Jenssen, el uso del microscopio llevó a Marcello al descubrimiento de los capilares.
-
En 1965 se modifica y da lugar a la carrera de Químico Bacteriólogo Parasitólogo que es como actualmente esta registrada y de ahí nace la primera generación de QBP en la UANL.
-
Científicos irlandeses clonan a la primera oveja llamada Dolly.
-
El 11 de mayo del 2017, tras meses de trabajo, la Facultad de Ciencias Biológicas de la UANL consigue la acreditación internacional de sus 4 carreras
A list shows items. A timeline shows sequence.
Use Timetoast to make dates, milestones, and turning points easier to understand in a clear visual format. Timetoast is a timeline maker for work, school, research, and stories.